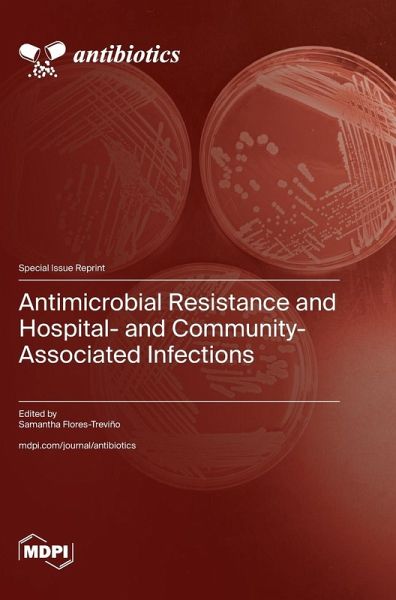

Antimicrobial Resistance and Hospital- and Community-Associated Infections
Versandkostenfrei!
Versandfertig in 1-2 Wochen
60,99 €
inkl. MwSt.
PAYBACK Punkte
30 °P sammeln!
The aim of this Special Issue is to provide updated information about antibiotic resistance in healthcare-associated infections or community infections worldwide. It is known that antimicrobial resistance is a significant threat to global human health. Particularly, ESKAPE pathogens include vancomycin-resistant Enterococcus spp. (VRE), methicillin-resistant Staphylococcus spp. (MRS), multidrug-resistant (MDR) Acinetobacter baumannii, MDR Pseudomonas aeruginosa, and carbapenemases and/or extended-spectrum betalactamase (ESBL)-producing Enterobacterales (CRE). There is an urgent need for the res...
The aim of this Special Issue is to provide updated information about antibiotic resistance in healthcare-associated infections or community infections worldwide. It is known that antimicrobial resistance is a significant threat to global human health. Particularly, ESKAPE pathogens include vancomycin-resistant Enterococcus spp. (VRE), methicillin-resistant Staphylococcus spp. (MRS), multidrug-resistant (MDR) Acinetobacter baumannii, MDR Pseudomonas aeruginosa, and carbapenemases and/or extended-spectrum betalactamase (ESBL)-producing Enterobacterales (CRE). There is an urgent need for the research and development of new and effective antibiotic treatments to combat these pathogens. In this Special Issue, the included reports assess current antimicrobial-resistance trends in hospital and community settings, including the frequency and transmission of MDR pathogens, particularly those with alarming resistance trends.